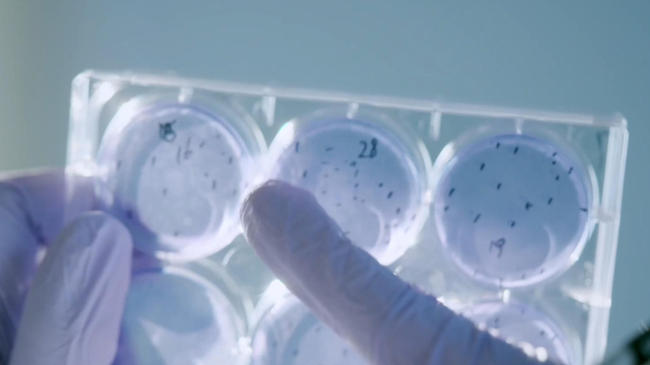
同筑健康防线丨一个传染17个！百日咳，每个家长都该警惕的“隐形炸弹”

点击右上角
微信好友
朋友圈

请使用浏览器分享功能进行分享

它是已知传染病中的“传播能手”,是家庭中的“隐形炸弹”。百日咳这个熟悉又陌生的疾病,你真的了解吗?
百日咳是由百日咳鲍特菌引起的急性呼吸道传染病,主要通过飞沫传播,也可通过密切接触传播。人是百日咳鲍特菌的唯一宿主。当患者在咳嗽,打喷嚏时,将细菌播散到空气中,易感者吸入带菌的飞沫而被感染。1679年,英国医学之父Thomas Sydenham根据百日咳患者在咳嗽时,试图闭合声门时产生的特征性的声音,将其命名为whooping cough(百日咳), 也就是半吼叫的咳嗽,强调的是该病剧烈咳嗽末尾出现的吸气性声音。

作为已知传染病中传染性最强的疾病之一,百日咳的基本再生数高达12-17,这意味着在免疫空白的人群中,平均每一个病人就能传染12-17个人。不仅如此,它的传染期较长,在发病初期传染性最强,传染性可持续到发生咳嗽后3周。百日咳不仅仅会引起剧烈的咳嗽,它对健康的危害远超想象,特别是在婴幼儿和免疫力低下的群体中,百日咳会引起一系列并发症,如肺炎,肺不张、呼吸暂停、百日咳脑病等。年龄越小,百日咳重症病例的比例越高,甚至造成死亡。

百日咳是《中华人民共和国传染病防治法》中在列的乙类传染病,它的传播模式随着疫苗时代的到来发生了转变。曾经儿童是主要的传染源,如今更多转变为青少年或成人向婴幼儿的传播模式。父母等家庭成员为百日咳的主要传染源。(庞聪)
